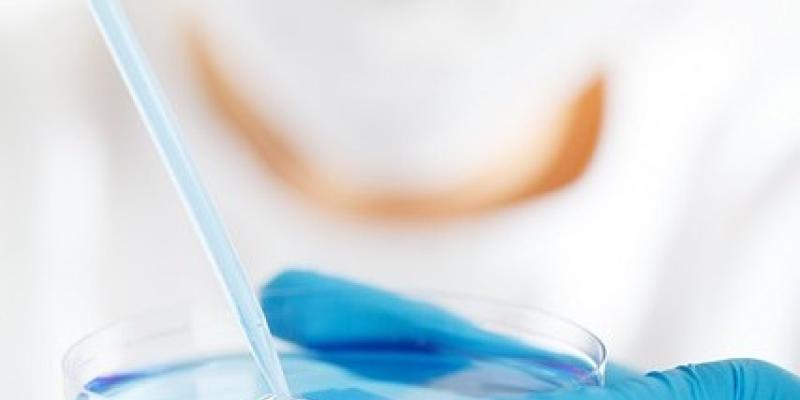
Los avances científicos más esperados

Lectura fácil
Los avances científicos son imparables, además de imprescindibles para el desarrollo del ser humano. 2023 promete y mucho en este aspecto, ya que el año pasado se iniciaron, o avanzaron de forma importante, una serie de proyectos en el ámbito de la medicina o la ciencia espacial, que esperan ver sus primeros y más importantes resultados a lo largo de este año.
5 avances científicos que se esperan alcanzar en 2023
Hoy te traemos esos 5 avances científicos que han destacado por encima de los demás y que, sin lugar a dudas, serán los protagonistas de 2023:
Una mirada fija y más precisa del espacio
La poderosa inquietud del ser humano por el espacio exterior prácticamente ha nacido con nosotros, ya que desde existimos como especie, hemos alzado la vista con curiosidad al manto oscuro plagado de puntos luminosos a los que hemos intentado darle un sentido en diferentes formas. Por supuesto, desde entonces y gracias a los avances científicos, el ser humano se encuentra cada vez más cerca de conocer, entender y explorar al menos nuestro entorno más cercano del universo.
Para este 2023, la Agencia Espacial Europa (ESA por sus siglas en inglés), quiere dar su propio salto de exploración enviado el 'Euclid', otro poderoso telescopio que orbitará durante 6 años para generar un mapa 3D de nuestro universo. Por otro lado, la Agencia de Exploración Aeroespacial de Japón, realizará sus primeras pruebas para detectar radiación de rayos X de estrellas y galaxias distantes.
Vacunas de nueva generación
Si la pandemia de coronavirus de 2020 ha podido tener algo de positivo, sin duda han sido los avances científicos en medicina, concretamente en los sistemas para mejorar la capacidad de fabricar vacunas. Con el éxito, tanto en velocidad como en eficacia de las vacunas, consideradas ya de nueva generación, creadas para frenar esta pandemia, otras enfermedades como la tuberculosis, el VIH o la fibrosis quística, entre otros virus altamente mortales, podrían tener la puerta abierta a su erradicación.
Una nueva era de misiones a la Luna
De la misma forma en la que la exploración espacial se está perfeccionado, también lo hacen otras misiones que llamaron la atención décadas atrás. Qué duda cabe de que la llegada del ser humano a la luna fue un gran hito para la humanidad. Ahora, la NASA ha querido dar otro paso con el programa Artemis, a través del que envió la cápsula Orión a la Luna, sin tripulación, y la devolvió a la Tierra en perfectas condiciones.
Esto ha abierto una puerta amplia a los viajes no tripulados hacia el espacio y para este año se espera el desarrollo de más misiones similares o incluso de los primeros vuelos civiles a la Luna, como el que prepara la empresa SpaceX de Elon Musk.
Vencer la batalla contra el Alzheimer
A finales de 2022, se celebró uno de los avances científicos más importantes en la lucha contra el Alzheimer, al dar con un fármaco capaz de ralentizar la destrucción de los tejidos neuronales provocados por esta enfermedad. A principios de este mes, en Estados Unidos, se dio luz verde a la utilización de este medicamento para empezar el tratamiento de personas con esta patología.
Otros medicamentos dirigidos a combatir esta enfermedad, se encuentran en desarrollo y se espera empezar a ver los primero resultados a lo largo de este año.
Ingeniería genética CRISPR
La ingeniería genética es cada vez más una realidad. La modificación de nuestro ADN para prevenir enfermedades o desordenes genéticos, es uno de los avances científicos que muy probablemente empiecen a desarrollarse de forma más avanzada en este 2023. Concretamente a través de la puesta en marcha de la terapia CRISPR-Cas9, que consistiría en una edición genética capaz de alterar la cadena de ADN para generar nuevas secuencias.



Añadir nuevo comentario